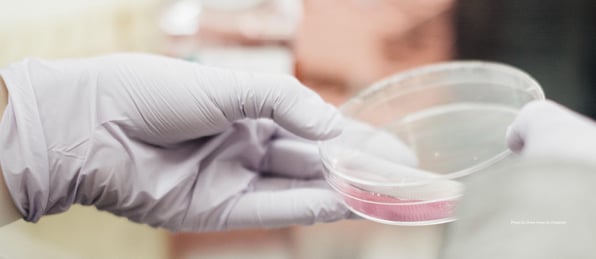

In this blog we will be discussing Chapter 18 of the ICD-10-CM
Healthicity Blog
Subscribe for Healthcare News, Simplified.
Search Results from the Blog
Posts by Vipin Bhardwaj:
ICD-10 Reminder Series: Section 1.C.16 & 17. Conditions Originating in the Perinatal Period and Congenital Malformations
October 1, 2019 | Posted by :
 Vipin Bhardwaj
Vipin Bhardwaj
ICD-10 Reminder Series: Section 1.C.6. Diseases of the Nervous System
April 30, 2019 | Posted by :
 Vipin Bhardwaj
Vipin Bhardwaj
ICD-10 Series: Section 1.C.2. Neoplasms
March 25, 2019 | Posted by :
 Vipin Bhardwaj
Vipin Bhardwaj
ICD-10 Series: Section 1. C.1. Certain Infections and Parasitic Diseases
February 12, 2019 | Posted by :
 Vipin Bhardwaj
Vipin Bhardwaj